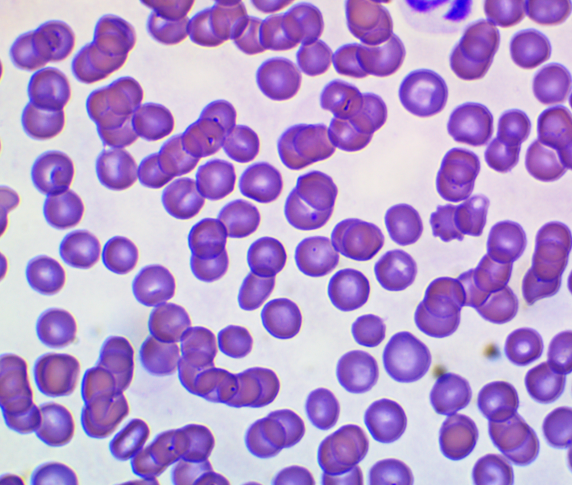
f145560b7e0f0bac7bbb285ed8ef4067_1771927787_0796.png f145560b7e0f0bac7bbb285ed8ef4067_1771927787_0796.png

강아지 면역매개성 혈소판감소증 치료 '혈소판이 한 개도 없다고?'
페이지 정보
본문
솜이, 이름처럼 하얗고 귀여운 8살령의 여아 포메라니안 강아지가 배쪽에 심한 멍이 들어서 본원에 내원했습니다.
처음에는 지역 병원에 내원했는데,
혈소판 수치가 33,000개/ul (본원 장비 기준 정상범위 148,000개/ul 이상이어야 정상범위)정도로 낮아져 있어서 저희 병원으로 의뢰되었던 환자입니다. 보호자님께 들어보니 오늘 미용을 갔는데, 배쪽에 심한 멍이 들어서 병원에 내원했다고 하셨습니다.
본원에서 다시 확인했을 때는 혈소판 수치가 0개였으며, 혈액 도말 검사 상에도 혈소판이 관찰되지 않았습니다.
의뢰병원에서 오는 2시간동안, 그나마 남아있던 혈소판이 다 사라진 것을 의미하며, 이만큼 질병의 진행이 빠를 수 있다는 점이 오늘 설명드릴 면역매개성 혈소판감소증의 무서운 점이라고 할 수 있습니다.
일반적으로 보호자님들이 내원하는 이유는 온몸에 멍이 들어서 오는 경우가 흔한 편입니다.
하지만, 면역매개성 혈소판감소증은 말 그대로 면역질환으로 혈소판이 줄어들어 출혈이 지속적으로 발생할 수 있다는 점이 무서운 점 입니다.
대표적으로는
- 피하 출혈(멍)
- 위장관 출혈(혈변)
- 코피
- 점막 출혈
- 심한 경우 폐 출혈도 발생할 수 있으며
- 피가 새어나가기 때문에 이차적으로 빈혈도 발생
할 수 있는 무서운 질환입니다.
▶ 면역매개성 혈소판감소증 진단
그렇다면 단순히 혈소판 수치가 0인 경우
면역매개성 혈소판감소증으로 진단을 하는 것일까요?
결론부터 말씀드리면 가능성은 높지만, 반드시 그렇지는 않습니다.
이 부분은 2024년 발행된 ACVIM ITP consensus에 상세하게 나와있습니다.

<자료 출처: ACVIM ITP consensus>
우선 혈소판 수치가 50,000개 이하이면서, 혈소판이 감소되는 다른 원인이 확인되지 않으면 이 경우 면역매개성 혈소판감소증을 추정진단할 수 있습니다.
이 말은 즉,
감염이나 염증 혹은 종양 등 혈소판을 감소시킬만한 원인이 있는가를 먼저 확인하는 것이 중요합니다.
이 강아지도 마찬가지로 이와 동일하게 접근을 시작했습니다.
- 우선적으로 혈소판 감소증을 유발할 수 있는 진드기 매개 질병에 대한 PCR 검사를 의뢰하고,
- 복부 초음파 검사를 통해 종양 등 다른 원인을 최대한 배제했으며,
- 혈액검사를 통해 전신 염증에 대한 가능성도 낮다고 판단하였습니다.
- 이렇게 증상을 유발 가능한 질병을 하나하나 배제하면서 진단하는 것을 배제적 진단이라고 합니다.

▶ 면역매개성 혈소판 감소증 치료
면역매개성 혈소판감소증은 말 그대로 면역매개성 질환이기 때문에 치료는 면역억압 치료를 통해 이루어집니다.
대표적인 면역억제제는
많은 보호자님들도 잘 아시는 Steroid계열 약물입니다.
또한 연구 결과에 따르면,
면역억제 용량의 Corticosteroid와 항암제를 함께 투여하면 혈소판이 40,000개까지 올라가는 시간이 줄어든다고 알려져 있습니다.
그 외에 치료에 도움을 줄 수 있는 방법으로는,
1. 골수에서 혈소판 생성을 자극하는 약물이 있으며,
2. 혈소판 파괴를 감소시킬 수 있는 정맥내 면역글로불린 약물도 있습니다.
이 두 약물 모두 어느정도 효과는 입증되어 있는 약물입니다.
일반적으로 혈소판이 다시 상승하는데 걸리는 시간은 Corticosteroid 단독 투여 시 평균 6.8+/-4.5일 이라고 알려져 있습니다.
다른 약물들과 병행 시 이 시간은 단축될 수 있다고 알려져있습니다. 하지만, 이는 통계적으로 알려진 기간이지 모든 환자가 이 기간 내에 반응한다는 것은 아닙니다. 면역억제제에 잘 반응하지 않는 경우도 있으며, 이 경우에는 혈장치환술이나 비장절제술이 고려될 수 있습니다.

<혈소판 추이 변화>
다행히 솜이의 경우에는
Corticosteroid, 항암제, 골수 반응 촉진제, 면역글로불린 약물 모두 첫 날에 투여했고,
3일 후 혈소판 수치가 40,000개 이상 증가된 것을 확인하였습니다.
혈소판이 잘 증가한다고 해도, 그 이후 치료도 중요합니다. 면역억제제를 조금씩 감량하면서 꽤 오랜 기간 동안 관찰해야하며, 면역매개성 질환이므로 당연히 재발하는 경우도 있습니다.
▶ 면역매개 혈소판감소증 위험성
면역매개성 혈소판감소증의 사망률은
10~30% 정도 사이로 알려져 있습니다.
이는 결코 낮은 수치가 아니며, 꽤 많은 아이들이 이 질환으로 사망할 수 있음을 시사합니다. 또한 위장관 출혈이 발생하거나, 빈혈수치가 낮은 경우 더 불량한 예후를 보인다는 연구결과가 있었습니다.
솜이의 경우에도 입원 후 2일 동안 빈혈과 관련된Hct 수치가 30%나 감소하였으며, 흑변을 보는 것으로 보아 위장관 출혈이 발생하고 있음을 추정할 수 있었습니다. 다행히 수혈을 1회 진행했고, 혈소판도 잘 증가하는 경향을 보여서 솜이는 추가적인 수혈 없이 잘 회복했습니다.
<좌: 수혈 중인 솜이, 우: 치료 잘 받고 있는 솜이>
솜이가 앞으로 약도 잘 먹고, 재발하지 않기를 기도하면서 잘 회복되기를 바라며 글 마무리하겠습니다.
긴 글 읽어주셔서 감사합니다.
- 이전글강아지 전십자인대 단열 수술 26.03.20
- 다음글강아지 환축추 아탈구(AAI) 수술 '2kg 말티푸, 갑자기 목을 못 들던 아이' 26.02.24